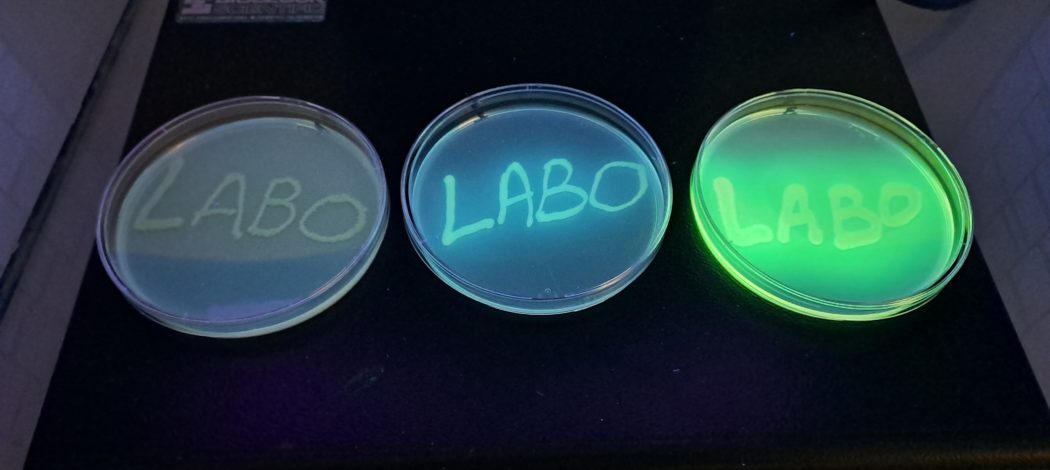

Ce jeudi 9 et vendredi 10 octobre, le lycée Jean Macé de Lanester a célébré la Fête de la Science.
Pour l’occasion, les étudiants de 1ère année de BTS Bio-Analyses en Laboratoire de Contrôle (BioALC) ont organisé plusieurs ateliers scientifiques, dans le cadre de leur premier projet de l’année.
Le thème national de cette édition était « L’intelligence ». Les étudiants se sont approprié le sujet à leur manière, en explorant l’intelligence du vivant : cette capacité qu’ont les organismes à s’adapter, se défendre, produire de la lumière ou transformer la matière grâce à des mécanismes naturels ingénieux.
Après plusieurs semaines de préparation : mise au point de protocoles, conception d’affiches et de supports de présentation, cinq ateliers ont vu le jour :
- la bioluminescence : quand la lumière révèle l’intelligence du vivant ;
- l’extraction d’ADN : la molécule de l’intelligence du vivant ;
- la chromatographie des pigments, l’intelligence des plantes face à la lumière ;
- la fabrication de billes colorées d’alginate : l’intelligence des matériaux du vivant ;
- et l’étude des euglènes et spirulines : l’intelligence microscopique du vivant.
Les collégiens invités ont été accueillis et guidés dans le lycée pour participer à ces activités. Répartis en petits groupes, ils ont pu observer, expérimenter et manipuler eux-mêmes, accompagnés par les étudiants de BTS qui leur expliquaient les étapes et les principes scientifiques.
Les visiteurs sont repartis ravis de leurs découvertes, et les étudiants, heureux de voir leur travail aboutir et apprécié.
Une belle expérience de partage et une première réussite pour cette nouvelle promotion d’étudiants.